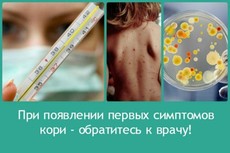

Осторожно, корь!
В связи со сложившейся эпидемиологической ситуацией министерство здравоохранения Иркутской области организовало проведение комплекса профилактических и противоэпидемических мероприятий, направленных на предотвращение распространения кори среди населения Иркутской области. Проводится дополнительная иммунизация населения, ежедневное наблюдение за контактными лицами. Так, только за период 31 декабря 2019 - 1 января 2020 года проведена дополнительная иммунизация 328 человек, 618 человек находятся под динамическим наблюдением медицинских работников.
Корь – одна из самых быстро распространяющихся среди непривитых граждан вирусных инфекций. Возбудитель кори – вирус, который передается воздушно-капельным путем, при чихании, кашле, во время разговора. Источник инфекции – только больной корью человек. Риску заболеть корью подвергается любой человек, не имеющий иммунитета к вирусу кори (непривитый или не болевший корью), даже при кратковременном общении с больным. Заразиться можно в автотранспорте, в магазине, а если в доме есть заболевший корью - то в подъезде или в лифте. Наиболее распространенные симптомы кори: повышение температуры тела до 38 градусов и выше, кашель, конъюнктивит, поэтапное появление сыпи. Источником инфекции является заболевший с последнего дня инкубационного периода заболевания до 5 дня с момента появления сыпи.
Важно понимать, что корь – это не только сыпь и лихорадка, которая проходит через несколько дней. Корь – это опасное инфекционное заболевание, которое может вызвать иммунную недостаточность, серьезные осложнения (пневмонии, а также тяжелые заболевания нервной системы - энцефалиты, приводящие к отеку мозга, менингиты, менингоэнцефалиты, полиневриты), вплоть до неблагоприятных исходов. Особенно тяжело болеют взрослые и дети грудного возраста. При заболевании беременной женщины возможно внутриутробное заражение плода, что опасно развитием осложнений и тяжелого заболевания у еще неродившегося ребенка.
Наиболее эффективная мера профилактики кори и ее осложнений – вакцинация.
Плановая иммунизация детей проводится в возрасте 1 год и в 6 лет. Взрослых, не болевших корью ранее, непривитых или привитых против кори однократно, прививают в возрасте до 35 лет. До 55 лет включительно прививают взрослых, относящихся к группам риска (медицинские работники, работники образовательных организаций и пр.). После двукратного введения вакцины, формируется стойкий длительный иммунитет к этой инфекции.
Всем лицам, бывшим в контакте с больным корью, не болевшим корью ранее, непривитым или привитым против кори однократно, без ограничений возраста проводится иммунизация против кори по эпидемическим показаниям в первые 72 часа с момента контакта с больным.
Для того, чтобы защитить себя от заболевания, медицинские работники рекомендуют сделать прививку против кори. Все, кто не имеет документального подтверждения о прививках против кори или перенесённом заболевании «корь», должны обратиться в поликлинику по месту жительства и сделать прививку. Вакцинация проводится бесплатно при наличии паспорта и полиса.
Если у взрослого или ребенка поднялась температура, появились симптомы заболевания с катаральными явлениями (головная боль, слабость, кашель) и/или сыпью, необходимо остаться дома и вызвать врача. Так окружающие будут защищены от распространения заболевания.